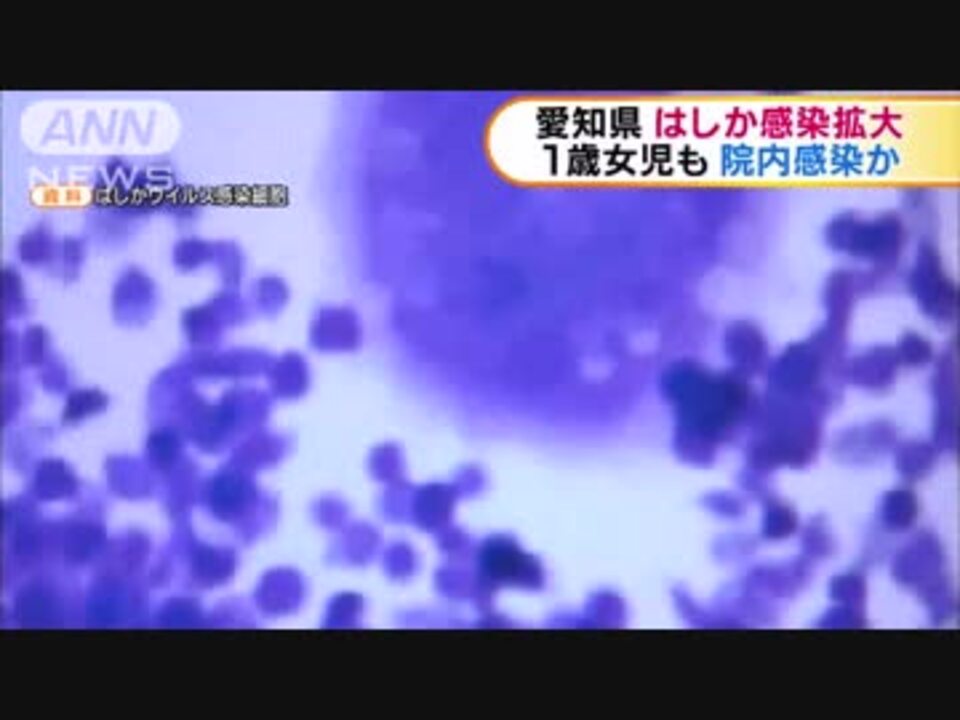

アマゾン

mzdonald s back number

ライブドアブログ livedoor

オレ的ゲーム速報 刃

socomの隠れ家

ニコニコ

して紹介する ニュース拾い読み 本日

gta4 そのサイトにアクセスすると大変なことに nicozon

paperzz com

ニコニコ

march 2010 the blog is ayaka

ニコニコ

2

オレ的ゲーム速報 刃

gtaiv street グランド セフト オート4 情報サイト gtaiv street 2周年記念 grand theft auto ivをプレゼント

アマゾン

ニコニコ

オレ的ゲーム速報 刃

paperzz com

漫画もアニメも海外でオワコンになりつつある7
ニコニコ

www tastes co il

yahoo 知恵袋 yahoo japan

gtaiv street グランド セフト オート4 情報サイト gtaiv street 2周年記念 grand theft auto ivをプレゼント

hinemosu

オレ的ゲーム速報 刃

gtaiv street グランド セフト オート4 情報サイト gtaiv street 2周年記念 grand theft auto ivをプレゼント

ケータイのアレ

ニコニコ

mzdonald s back number
You May Like